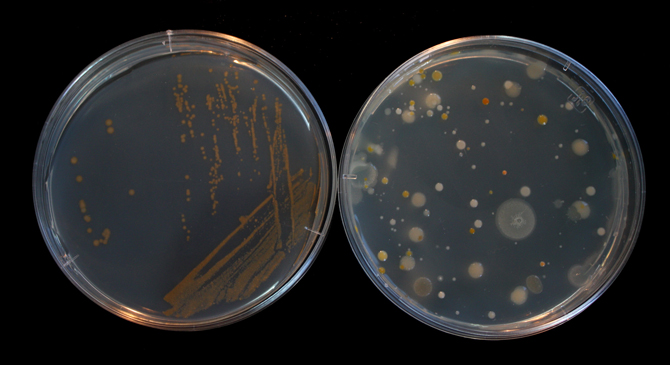

Què és el que veiem quan agafem aigua de mar amb un got? Res … aigua …. Però malgrat això en aquesta aigua transparent hi ha milers de milions d’éssers vius microscòpics invisibles a simple vista que tenen un paper essencial en el funcionament del planeta.
Tradicionalment, la diversitat de bacteris marins s’ha estudiat realitzant cultius amb aigua de mar en plaques de petri, com les que veus a la foto següent. Per a fer-ho s’utilitza aigua de mar esterilitzada, a la qual s’hi afegeixen uns nutrients especials i agar (un extracte d’algues marines que serveix per a solidificar el medi de cultiu). Un cop tenim les plaques, podem afegir l’aigua de mar que volem estudiar.
A la part esquerra d’aquesta foto hi podeu veure una placa de petri amb un cultiu pur d’un bacteri marí, i a la de la dreta, un cultiu d’una mostra d’aigua de la badia de Blanes, a Girona. Els diferents punts són colònies formades per milions de bacteris.
A la placa d’aigua de mar (dreta) n’hi ha de diferents mides i colors! Les diferents mides indiquen que unes colònies creixen més ràpid que altres i les acolorides indiquen que els bacteris que les formen contenen pigments. El cultiu pur de l’esquerra és de color taronja perquè té carotens, el mateix pigment que hi ha a les pastanagues.
CONSTRUINT UN ZOO MICROBIÀ
Vols veure una part d’aquesta diversitat invisible? Doncs pots fer-ho a la teva pròpia cuina! Només necessites tenir un mar a prop per agafar una mica d’aigua de mar ….
Es poden fer plaques de petri casolanes utilitzant coses que pots aconseguir en un supermercat normal: recipients d’un sol ús, brou de carn, gelatina i sucre.

Pels contenidors pots utilitzar tapers transparents amb tapa, gots de plàstic transparent coberts amb bosses de plàstic o qualsevol recipient transparent que puguis tapar ( serien l’equivalent a les plaques de petri que utilitzem al laboratori). Nosaltres hem utilitzat tapers. L’única cosa important és que siguin resistents a la calor perquè hi posarem un líquid calent.
Començarem fent el medi on creixeran els bacteris
1. Escalfa mig litre d’aigua de mar en un microones o en un cassó al foc fins que bulli o estigui a punt de bullir.
2. Afegeix la gelatina (el doble del que afegiries en la recepta que apareix en el paquet), el cub de brou de carn i el sucre i remou fins que es barregi tot bé.
3. Un cop barrejat cal filtrar el medi per retirar el greix que genera el brou de carn. Agafa un embut, recobreix-lo per dins amb paper de cuina i afegeix el líquid (posa’t un guant de cuina que crema!). Si no tens un embut ho pots fer amb un colador.

4. Un cop filtrat agafa el recipient amb cura i distribueix el medi de cultiu en els diferents contenidors.
5. Tapa els recipients amb la tapa deixant la cantonada una mica oberta i quan estiguin freds fica’ls a la nevera perquè es solidifiqui la gelatina. Deixa’ls una nit a la nevera.
El dia següent sacseja la condensació de la tapa del recipient i torna-la a posar sense tancar-la completament. Deixa els recipients una hora amb la tapa superposada perquè s’assequi bé la gelatina.
Quan les plaques estiguin seques ja pots començar a sembrar!
6. Agafa un escuradents de les orelles, submergeix-lo en un pot amb aigua de mar i frega’l suaument sobre la gelatina com es mostra a la foto:

Quan acabis posa-li la tapa al recipient (superposada, no tancada completament). Comprova les plaques cada dia per veure si hi ha crescut alguna cosa…
Això és el que va passar en la nostra placa al cap de dos dies:

També pots crear zoos microbians de l’ambient que t’envolta. Quantes vegades has sentit que cal rentar-se les mans amb freqüència? Hi ha bacteris per tot arreu. Un percentatge petit són patògens (poden produir malalties), però la gran majoria no ho són.
Vols veure què creix al teu voltant?
Repeteix tot el procés però aquesta vegada prepara el medi de cultiu amb aigua de l’aixeta en comptes d’aigua de mar. Pots marcar la part de baix del recipient amb un retolador i dividir-lo en seccions per fer microzoos de diferents mostres en una mateixa placa.
Per exemple, en aquesta placa pots fer un zoo microbià del teu dit abans i després de rentar-te les mans:

També pots provar fregant l’ escuradents de les orelles a la pila de la cuina, o en el pom de la porta o en el teclat de l’ordinador i veuràs que creix al teu voltant!

Bon dia a tothom!
Sóc una noia de 12 anys que va a 1r d’ ESO. Que experiment tan interessant, segurament el provaré a fer a casa. Espero que em surti bé. Gràcies per publicar-lo Marta.
Paula Indias
Bones Marta. M’ha agradat molt la idea…..podries donar-me les quantitats de sucre que s’ha de ficar ..soc un pare que he fet biologia i estic pensant anar a l’escola dels meus fills per fer unes pràctiques……Moltes gràcies
Són dues cullerades de sucre. Espero que amb aquesta informnació puguis realitzar l’experiment!
Hola Marta.
M’ha encantat el teu experiment en el qual crees un zoo microbià. Sobre tot pel que fa a la quotidianitat dels ingredients per fer els medis de cultiu. Sóc professora de Ciències Naturals de Secundària. Quan pugui intentaré fer una pràctica amb els meus alumnes basant-me en aquest experiment. Si vols ja et faré saber si m’ha funcionat… Gràcies per la idea. Laia Jarque